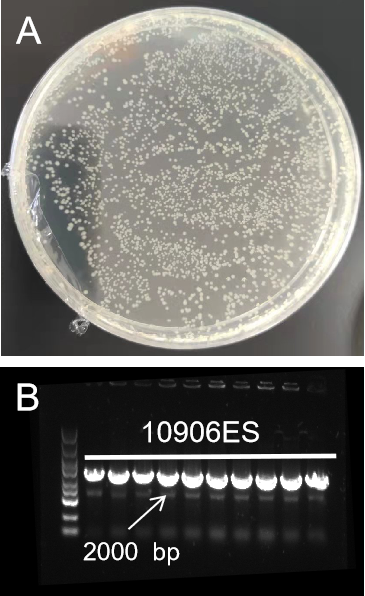
新闻图片3

翌圣生物科技(上海)股份有限公司品牌商
19 年
手机商铺
- NaN
- 0.7999999999999998
- 1.7999999999999998
- 0.7999999999999998
- 3.8
翌圣生物科技(上海)股份有限公司
入驻年限:19 年
- 联系人:
翌圣生物
- 所在地区:
上海
- 业务范围:
体外诊断、耗材、技术服务、抗体、ELISA 试剂盒、细胞库 / 细胞培养、试剂
- 经营模式:
生产厂商
推荐产品
公司新闻/正文
涨知识 | 克隆专题三:分子克隆载体、片段制备方法
1723 人阅读发布时间:2023-10-31 08:30
克隆技术,又称为“生物放大技术”,目前应用最广泛的技术为“分子克隆”,即通过重组技术将目的DNA片段按照人们的设计定向连接起来,在特定的受体细胞中与载体同时复制并得到表达,产生新的遗传性状的技术。
前两期小翌给小伙伴们介绍了一些传统的、应用范围广的、新型的分子克隆方法。相信大家已经发现,大部分的分子克隆方法,诸如传统分子克隆、TA克隆、Gatway克隆、TOPO克隆、无缝克隆等都绕不开目的片段制备、载体制备、连接、转化、筛选等等步骤,接下来小翌就具体解析一下载体和目的片段制备的过程,为您的实验提供好方法。

图1.无缝克隆关键步骤
01 目的片段制备
目的片段:目的片段来源为基因组DNA、另一质粒的一部分或者线性DNA片段等。制备目的片段时常用的方法有两种,方法一是通过PCR扩增片段或者载体上的目的序列,在此过程中,如果制备目的片段是为了在下游进行传统的酶切酶连方式,就需要引入限制性酶切位点,设计与线性载体两端相同的酶切位点,以便酶切后通过匹配的粘性末端进行连接;如果制备目的片段是为了在下游进行同源重组,则需要引入15-25 bp的上下游同源臂。
方法一
首先,通过翌圣官网的无缝克隆引物设计软件(https://www.yeasen.com/hieff-clone/)设计引物。输入需要的载体序列和目的片段序列,选择合适的酶切位点,生成引物,如图2所示。

图2.翌圣官网引物设计流程
值得注意的是,多个目的片段插入的双酶切位点,实际添加到第一个片段的5’端和最后一个片段的3’端,中间片段不含有设计的酶切位点。之后,通过引物合成公司合成需要的引物序列。接着,利用PCR技术扩增目的片段,如使用翌圣高保真PCR试剂盒(Cat#10164ES),包含高保真DNA聚合酶,扩增目的片段快速简便、灵敏度高、特异性强;或使用翌圣快速PCR试剂盒(Cat#10157ES),3 kb以内基因组等复杂模板扩增速度可达1-3 sec/kb,5 kb以内质粒等简单模板扩增速度可达1 sec/kb,具有Taq DNA聚合酶,扩增后的PCR产物具有3’-dA突出端,可轻松克隆至T载体。
方法二 通过限制性内切酶,对质粒进行限制性酶切,获得需要的目的片段,直接应用于下游的载体片段连接,如TOPO克隆技术,翌圣通用型TOPO克隆试剂盒(Cat#10906ES)不受酶切后的平末端或粘性末端的影响,仅需5 min就能连上载体,市场反馈效果好,南京某高校利用10906ES连接2000 bp(50 ng)粘性末端片段,阳性克隆率达100%,如图3所示。
图3. 10906ES连接2000 bp(50 ng)粘性末端片段图
A:载体和片段均来自南京某高校;B:插入片段PCR鉴定电泳图
扩增后产物需要进行纯化。有两种方法,一种是使用翌圣琼脂糖(Cat#10208ES)配制凝胶,电泳后切割出目标片段进行纯化,如使用翌圣的琼脂糖凝胶回收试剂盒(Cat#19101ES)能保证实验流程高效、结果可靠、得率高。另一种是直接取PCR产物纯化,如使用翌圣PCR产物纯化试剂盒(Cat#19106ES),操作简便,15 min即可完成PCR产物纯化。
02 载体制备
载体:将目的DNA序列通过基因工程手段送到受体细胞所需的运载工具。常见的载体有质粒,病毒和噬菌体。当前基因工程中最常用的载体是质粒。
所有基于质粒的克隆载体包括:确保在细菌宿主细胞内能有效增殖的复制原;单一酶切位点,或多克隆位点(MCS),后者含有一系列酶切位点,可供目的片段插入;载体成功转化后的细菌筛选标记(例如,抗生素耐受)。
pET系列载体是目前应用最广泛的重组蛋白表达载体,载体构建时目的片段被克隆入载体噬菌体T7转录翻译系统下,经转化在宿主T7 RNA聚合酶的诱导下进行表达。T7 RNA聚合酶具有超强并特异的启动T7启动子基因表达功能,当其被完全诱导时,可使宿主本身的表达几乎全部转化为目的基因的表达,诱导几个小时后即可使得最终目的基因表达产物超过细胞总蛋白的50%。
翌圣pET-28a(+) Vector表达载体(Cat#11905ES)载体带有一个N端的His/Thrombin/T7蛋白标签,同时含有一个可以选择的C端His标签,还有单一的多克隆位点,方便目的片段的克隆与表达,载体图谱如图4所示。

图4. 翌圣pET-28a(+) Vector表达载体图谱
准备好载体后,即可进行载体的制备。其与目的片段制备方法相同,可通过PCR扩增或限制性内切酶酶切获得线性化载体。限制性内切酶的选择取决于载体和插入片段上是否存在相应的识别序列、识别序列的位置以及是否适于连接。MCS往往是插入片段的首先选择,因为该区域专用于克隆。
翌圣的FuniCut™快速限制性内切酶能快速、精准完成DNA切割。载体酶切后,为防止自连,有必要进行载体的去磷酸化,尤其当载体酶切后末端可互补或是平端时。载体的去磷酸化对于降低背景、促进所需片段插入载体非常重要,翌圣小牛肠碱性磷酸酶(Cat#10321ES)可将DNA、RNA的5’端磷酸基团去除,有效阻止载体的自连现象。获得的线性化载体也需要纯化回收后使用。


图5. 小牛肠碱性磷酸酶去DNA磷酸化示意图
经过上述步骤,载体和目的片段都已整装待发,是时候开展下一步的载体和片段连接反应了。那么连接反应中应用到的技术和试剂又有哪些呢?关注我们,小翌会在下一期的分子克隆技术专题中给大家具体讲解分子克隆连接中应用到的技术,为您的实验带来新的思路与方向,期待下一次的见面~
03 相关产品列表
| 产品定位 |
产品名称 |
产品货号 |
规格 |
| 5s/kb,高保真PCR(含上样染料) |
2× Hieff Canace® AdvanceFast PCR Master Mix (With Dye) |
10164ES03/08 |
1 mL/5×1 mL |
| 快速PCR,快至1s/kb |
2×Hieff® Ultra-Rapid HotStart PCR Master Mix(with Dye) |
10157ES03/08 |
1 mL/5×1 mL |
| 常规PCR |
2×Hieff® PCR Master Mix(With Dye) |
10102ES03/08 |
1 mL/5×1 mL |
| 兼容TA/平末端克隆 |
Hieff Clone® Universal Zero TOPO TA/Blunt Cloning Kit |
10906ES08/20 |
5 T/20 T |
| 高质量琼脂糖 |
Agarose琼脂糖 |
10208ES60/76 |
100 g/500 g |
| 琼脂糖凝胶回收试剂盒 |
MolPure® Gel Extraction Kit 琼脂糖凝胶回收试剂盒 |
19101ES50/70 |
50 T/200 T |
| PCR产物纯化试剂盒 |
MolPure® PCR Purification Kit PCR产物纯化试剂盒 |
19106ES50/70 |
50 T/200 T |
| 表达载体 |
pET-28a(+) Vector 表达载体 |
11905ES03 |
1 μg |
| 去DNA磷酸化 |
Alkaline Phosphatase(30 U/μl),Calf Intestine(CIAP) 小牛肠碱性磷酸酶 |
10321ES80 |
1000 U |
| 通用缓冲液,5min完成精准酶切 |
FuniCut™快速限制性内切酶 |
15001ES-15051ES |
50 T |








